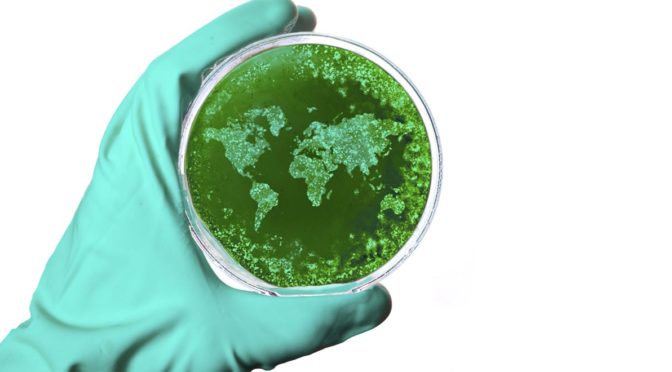

Details on the delivery of a $500 million biomedical fund, the first cab off the rank for the National innovation and Science Agenda, were discussed Monday 8 Feb at the AusBiotech Biomedical Fund briefing in Sydney and Melbourne.
The Biomedical Translation Fund was announced on December 7 2015. It allocates $250 million of the funds that were previously part of the Medical Research Future Fund (MRFF) to help bring Australian R&D in life sciences to commercial outcomes.
A team of fund managers will ensure the government’s investment is matched dollar for dollar by private investment, and the MRFF is expected to be fully funded once more from 2018-19. The government and private investment hope to bring in a revenue base “in the billions” in the next few years, according to Bill Ferris, the Chair of Innovation and Science Australia.
Plus the pool of money available to help Australia’s biotech industry to navigate the two ‘valleys of death’ – stages of research development and clinical trains that have stonewalled innovation in Australia – could be much greater, says Brigette Smith, Managing Partner of GBS Venture Partners.
“This is potentially a $2.5 billion investment in Australian technology,” she says, adding that traditionally every $1 equity from Australian investment attracted $5 from international partners.
“The absence of funds has been soul destroying” says Julie Phillips, Chair of AusBiotech and CEO of Australian biopharmeceutical company BioDiem.
Biomedical fund was the missing piece
Bill Ferris was instrumental in calling for the fund through the Government’s McKeon Review – Strategic Review of Health and Medical Research – Better Health through Research in 2013. He told the briefing this morning that there has been “lots of R and negligible D’ in terms of Australian Research & Development.
Ferris says the two valleys of death occur at preclinical phase (Death Valley 1) where a lack of funding inhibits development, and at advanced preclinical Phase I and Phase II in-human trials (Death Valley 2). The fund will “encourage people to give it a go at Death Valley 1 and bridge Death Valley 2” he says.
“It will support Australian technology to remain in Australia for longer, boost nano-engineering and advanced manufacturing and improve Australia’s health outcomes in the medium- to long-term,” he adds.
Details of the fund were released at the event today, in both Sydney and Melbourne. The fund will be delivered through several fund as yet un-named fund managers, with $50-$125 million of taxpayer’s money each, who will then seek similar private investment.
The funds will be delivered to companies with strong Australian input with the aim of creating jobs and pushing through innovation. The find will operate over an average of 7 and maximum of 15 years.
“This $500 million initiative will fuel an exciting development for biotech, med tech and venture capitalism,” says Ferris, who is also Co-Chairman and Co-founding partner of CHAMP Private Equity.
“It will reduce the innovation death rate and reduce the need for our innovation to be carried offshore.”
– Heather Catchpole